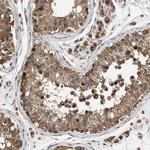
DUSP14 Antibody in Immunohistochemistry (Paraffin) (IHC (P))

Search
Invitrogen
DUSP14 Polyclonal Antibody
{{$productOrderCtrl.translations['antibody.pdp.commerceCard.promotion.promotions']}}
{{$productOrderCtrl.translations['antibody.pdp.commerceCard.promotion.viewpromo']}}
{{$productOrderCtrl.translations['antibody.pdp.commerceCard.promotion.promocode']}}: {{promo.promoCode}} {{promo.promoTitle}} {{promo.promoDescription}}. {{$productOrderCtrl.translations['antibody.pdp.commerceCard.promotion.learnmore']}}
产品信息
PA5-82706
种属反应
宿主/亚型
分类
类型
抗原
偶联物
形式
浓度
规格
纯化类型
保存液
内含物
保存条件
运输条件
RRID
产品详细信息
Immunogen sequence: LPRTLMAPRM ISEGDIGGIA QITSSLFLGR GSVASNRHLL QARGITCIVN ATIEIPNFNW PQFEYVKVPL ADMPHAPIGL YFDTVADKIH SVS
Highest antigen sequence indentity to the following orthologs: Rat - 96%, Mouse - 94%.
靶标信息
In addition to antigen recognition by the T-cell receptor, T-cell activation requires a second signal from a costimulatory receptor, such as CD28 (MIM 186760), which interacts with B7-1 (CD80; MIM 112203) and B7-2 (CD86; MIM 601020) ligands on antigen-presenting cells. CD28 costimulation induces transcription of interleukin-2 (IL2; MIM 147680) and stabilizes newly synthesized IL2 through the activation of mitogen-activated protein kinases (MAPKs), such as ERK (e.g., MAP2K4; MIM 601335) and JNK (see MIM 601158), and the subsequent creation of AP1 transcription factor (see MIM 165160). DUSP14 is a negative regulator of CD28 signaling.
仅用于科研。不用于诊断过程。未经明确授权不得转售。
篇参考文献 (0)
生物信息学
蛋白别名: Dual specificity protein phosphatase 14; DUSP14; MAP kinase phosphatase 6; Mitogen-activated protein kinase phosphatase 6; MKP-1-like protein tyrosine phosphatase; MKP-6; MKP-L; unnamed protein product
基因别名: DUSP14; MKP-L; MKP6
UniProt ID: (Human) O95147
Entrez Gene ID: (Human) 11072